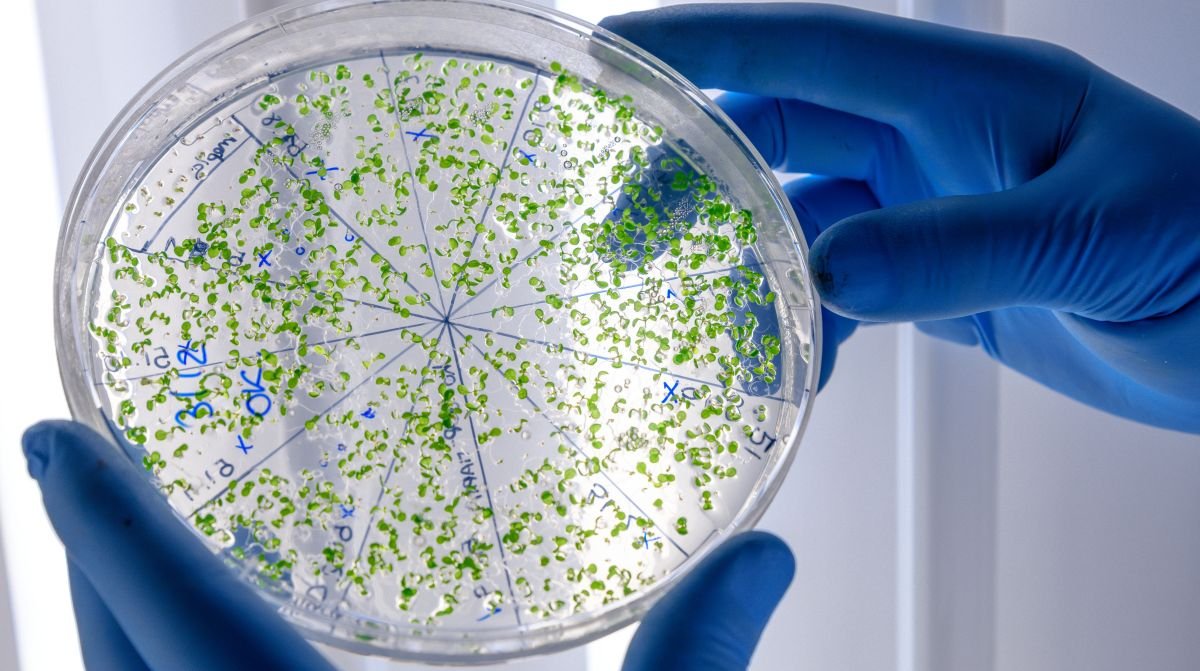

Paryžius. Prancūzų mokslininkai tiria naujas biologinės kilmės trąšas, kurios apsaugotų nuo aplinkos taršos, taupytų energiją ir sumažintų Europos priklausomybę nuo Rusijos importo.
Vakarų Prancūzijos regione ūkininkai dalyvauja eksperimentiniuose tyrimuose ir vietoj trąšų išbando miltelius, gautus iš pieno perdirbimo gamyklų nuotekose užaugintų dumblių. Rezultatai teikia daug vilčių. Sumaišius produktą su mineralinėmis trąšomis, pastarųjų poreikis sumažėja 25 proc., nekenkiant derliui, skelbia naujienų portalas „Euronews“.
Vienaląsčiai dumbliai auginami nuotekose, gautose iš pieno perdirbimo gamyklų. Mikroorganizmai įsisavina likučiuose esančias organines medžiagas ir paverčia jas naudinga biomase. Vėliau žaliava džiovinama iki miltelių ir paskleidžiama laukuose kaip natūrali trąša su gausiu azoto kiekiu.
Kviečių pasėliuose atlikti tyrimai atskleidė, jog dumblių milteliai neprilygsta mineralinėms trąšoms ar kitiems organiniams produktams, tačiau sumaišius su gamykliniais ingredientais santykiu 3:1 išlaikomi tokie patys derlingumo rezultatai.
Naujovė pateiks ūkininkams naujų iššūkių. Skirtingai nuo mineralinių trąšų, iš kurių azotas išsiskiria akimirksniu, todėl lengva dozuoti, iš dublių veikliosios medžiagos atsipalaiduoja lėčiau. Norint pritaikyti praktikoje, reikės didesnio išmanymo ir patirties. Vis dėlto, potencialas – akivaizdus. Kadangi produktas yra dehidratuotas, galima transportuoti ilgus atstumus, sandėliuoti ir naudoti netoli vietovių, kuriose ribojama nuotekų dumblo, kitų organinių trąšų sklaida.
Technologija gali pasiūlyti alternatyvą įprastinei trąšų gamybai, kuri remiasi taršiais ir energiją eikvojančiais procesais. Manoma, kad susigrąžindama maisto medžiagas iš nuotekų bei kurdama biologinės kilmės trąšas, Europa gali sumažinti priklausomybę nuo importo, sušvelninti poveikį aplinkai bei padidinti maisto sistemų atsparumą.
Taip pat šia tema skaitykite
-
Vietoj tradicinių pašarų – visus metus kviečių želmenys?
2026-01-23 -
Kaip tiksliai paskirstyti trąšas dirvoje
2026-01-21 -
Skirtingo potencialo žieminių kviečių auginimo technologijos
2026-01-16
Skaitomiausios naujienos
-
Kaip įsigyti valstybinę žemę
2026-01-20 -
Ūkininkams numatoma išmokėti 19 mln. Eur
2026-01-07 -
Afrikinis kiaulių maras pasiglemžė Lietuvos paveldą
2026-01-09




(0)